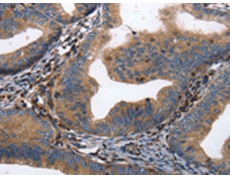
一抗

|
Background: |
Collapsin response mediator protein 3 is an enzyme that in humans is encoded by the CRMP3 gene.It is necessary for signaling by class 3 semaphorins and subsequent remodeling of the cytoskeleton.And plays a role in axon guidance, neuronal growth cone collapse and cell migration.Homotetramer, and heterotetramer with CRMP1, DPYSL2, DPYSL3 or DPYSL5. Interacts with PLEXA1. Phosphorylated upon DNA damage, probably by ATM or ATR. |
|
Applications: |
ELISA, WB, IHC |
|
Name of antibody: |
DPYSL4 |
|
Immunogen: |
Synthetic peptide of human DPYSL4 |
|
Full name: |
dihydropyrimidinase-like 4 |
|
Synonyms: |
CRMP3, DRP-4, ULIP4 |
|
SwissProt: |
O14531 |
|
ELISA Recommended dilution: |
1000-5000 |
|
IHC positive control: |
Human cervical cancer and Human ovarian cancer |
|
IHC Recommend dilution: |
25-100 |
|
WB Predicted band size: |
62 kDa |
|
WB Positive control: |
Human fetal brain tissue |
|
WB Recommended dilution: |
500-1000 |


 購物車
購物車 幫助
幫助
 021-54845833/15800441009
021-54845833/15800441009